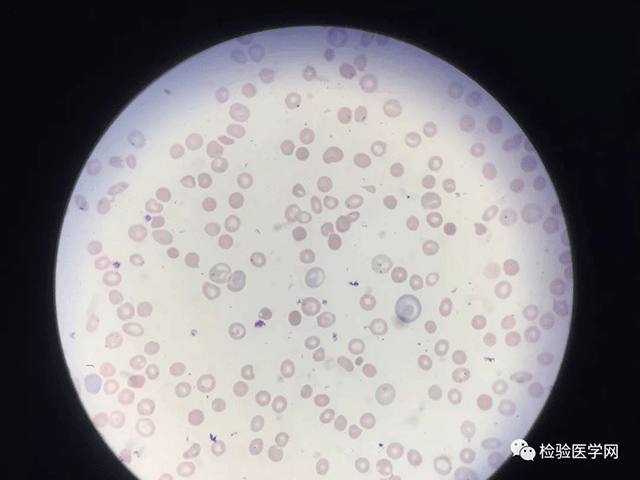

糖糖探案之真假血小板
近日,仪器班的老师告诉我,有个病人的血常规血小板1000多,我做了个荧光PLT复查后有血小板降到正常了,我立即将仪器上的检测结果调出来查看,如下图:

初次结果
引起血小板假性增多的原因常见于以下三个方面:
(1)血液中出现了较多的红细胞碎片或小红细胞增多,这些碎片或小红细胞在计数时会被划分到血小板的区域里,从而干扰了血小板的计数,导致仪器计数假性增高。
(2)输入脂肪乳后立即采血检测,乳糜颗粒也被仪器误认为是血小板,从而使血小板计数假性升高,这种情况也见于奶粉代替母乳的小孩,奶粉颗粒也可以被误认为血小板而导致假性增多。
(3)冷球蛋白血症导致的血小板增多,文献报道冷球蛋白血症患者的血液室温放置60min后可形成不定形物及不规则形红细胞IgM导致的血细胞分析仪测定血小板假性增多。
根据直方图我们认为是小红细胞干扰,于是用荧光血小板计数复查该样本,复查结果如图:

第一次复查结果
患者样本经过荧光血小板计数后变为144X109/L,与初次检测结果相差太大,于是当班老师再次进行了复查,如下图:

第二次复查结果
两次复查结果为何RBC相差较大呢?
先不说数值变化差异之大,就血小板和红细胞直方图都很异常。RBC呈现出双峰,PLT尾部翘起,明显的小红RBC干扰,再看看,RBC参数,MCV、MCH和MCHC均较低,HGB低而RBC数量正常,明显的小低贫血,但是真的是这样吗?我们将血样涂片镜检,如图所示:

此病人,红细胞严重大小不均,以大红细胞和小畸形红细胞比例较多,正常红细胞少见,红细胞可达正常红细胞的2-3倍,小红细胞又以碎片状,泪滴状红细胞为主,故认为红细胞形态严重异常,是导致PLT1000多的主要原因。但是我们通过RBC和PLT直方图不难发现异常,于是我们做了荧光血小板计数F-PLT,还进行了PLT手工计数,手工计数142,与仪器147和144相吻合,于是按照手工计数结果发放报告。并标注涂片镜检结果。
我们看到RBC flag出现多个报警提示:

红细胞多个参数出现*,*表示这些参数可靠性低。

同时红细胞提示:
RBC Abn Distribution 红细胞直方图异常
Anisocytosis 红细胞大小不均
Anemia 贫血
Iron Deficiency? 可能缺铁
Fragments? 红细胞碎片
再回过头来细看这些提示,基本已经将我们血涂片镜检结果描述的八九不离十,说明仪器可靠性已相当高,但是为何还会出现初次结果PLT 1000多的异常数值呢,这个问题充分说明了检验方法的局限性,遇到特殊病例,我们不能以通常的思维去判断一个问题,甚至是公认的原则,不能完全相信一种检测方法或原理,而应该综合多种方法,互补各种方法的局限造成结果的偏差,例如阻抗法只能根据细胞的体积大小检测细胞的数量,相比荧光染色结合流式细胞的方法就显得更加精准,但即使如此,RBC计数也出现了两次复查结果不一致的情况,我们将红细胞用生理盐水进行了200倍稀释后手工计数为4.4×1012/L,与仪器第二次复查结果相符。
由此可见,涂片镜检及手工计数仍然无法替代的金标准。当我们遇到比较特殊的病例标本时,一定不要忽视了仪器的报警信息,学会运用仪器给出的报警提示,帮我们迅速作出准确可靠的判断,然后根据仪器提示信息进行手工法复检,将二者有机结合既可提高效率,又可提示复检的大致方向,从而分析出准确可靠的检验结果。
【参考文献】
1.张时民,血小板计数阻抗法还是光学法准,有时真的不绝对! 检验医学网,2017-09-14.
2.付兆强,闫伟,汤小山,等. 冷球蛋白致血小板计数假性增多1例的分析[J]. 检验医学与临床,2017,14(22):3393-3395.
作者:天门市第一人民医院检验科 朱名超 黄银娥

